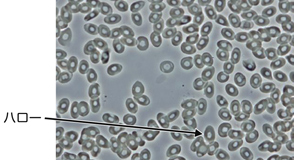
図12 位相差観察（ポジティブコントラスト）による生細胞（カエル血球）

Variety of microscopes (Japanese text only)
顕微鏡の種類と用途
この回では、顕微鏡には用途、形、観察方法に応じたさまざまな種類があることを知り、それらの顕微鏡がどのように利用されているかを学習する。
なお、ここでは光学顕微鏡について取り上げる。
1.顕微鏡の種類
1-1.用途による分類
何を観察するかによって、使用する顕微鏡の種類は異なる。
大きく分けると、細胞や細菌などを観察する生物顕微鏡と、金属や半導体などを観察する金属顕微鏡がある。
生物顕微鏡
生体組織の薄切切片や細胞、細菌など光を透過する物体の観察に用いる。
薄切切片や細胞、細菌などはプレパラート標本(ページ下 2-1.プレパラート標本の種類
参照)で、培養細胞は培養容器に入れて観察する。
生物顕微鏡では標本の下に照明があり、標本を透過した光によって標本の像を観察する。このように透過光によって標本を観察するため、「透過型顕微鏡」とも呼ばれる。
 図1 生物顕微鏡 |  図2 生物顕微鏡の観察例 |
金属顕微鏡
金属表面や半導体など、光を透過しない物体の観察に用いる。
金属顕微鏡では、対物レンズと同じ側に照明があり、標本から反射された光によって標本の像を観察する。このように落射(反射)照明で標本を観察するので、「落射型顕微鏡」、または「反射型顕微鏡」とも呼ばれる。
|
|
コラム:拡大像を立体的に見る「実体顕微鏡」
昆虫の観察など、サンプルをそのまま観察する場合には、実体顕微鏡が便利である。
|  図5 実体顕微鏡 |
1-2.形による分類
正立型顕微鏡
対物レンズの先端が下を向いていて、標本を上から観察する構造になっている。
標本の下から照明をあてて観察する。
プレパラート標本(ページ下 2-1.プレパラート標本の種類 参照)の観察に適する。
 図6 正立型顕微鏡(生物顕微鏡) |  図7 正立型顕微鏡(金属顕微鏡) |
倒立型顕微鏡
対物レンズの先端が上を向いていて、標本を下から観察する構造になっている。
ステージの下に対物レンズがあり、標本の上から照明をあてて観察する。
シャーレなどの培養容器での観察に適する。
 図8 倒立型顕微鏡(生物顕微鏡) |  図9 倒立型顕微鏡(金属顕微鏡) |
1-3.観察方法による分類
顕微鏡で標本を観察する場合、何をどのように観察したいかによって、使用する顕微鏡や観察方法が異なる。
標本の状態や観察の目的によって、適した観察方法を選択する必要がある。
明視野観察法(BF:Bright Field microscopy)
光学顕微鏡によるもっとも一般的な観察方法で、染色した標本から色と明るさの情報を得て観察する。
視野全体が照明によって明るく見える。
ただし、標本を染色した状態で観察するため、実際の標本の色とは異なることを覚えておく必要がある。
暗視野観察法(DF:Dark Field microscopy)
|
無染色標本の観察やバクテリアなどの細菌の検出に適した観察方法である。
特殊な照明で対物レンズには直接光を入れず、側面から標本に光を当て、標本によって散乱・回折(顕微鏡の基礎知識_顕微鏡の光学原理 ~光の性質~1-3.光の干渉と回折 参照)した光を観察する。 暗い視野の中に標本の像だけが明るく輝いて見える。 |  図11 暗視野観察による無染色の藻(アオミドロ) |
位相差観察法(PC、PH:Phase Contrast microscopy)
無色透明の標本や生きている細胞などの観察に適した観察方法である。
明るい背景の視野に標本が暗く見える観察方法(ポジティブコントラスト)と、暗い背景の視野に標本が明るく見える観察方法(ネガティブコントラスト)がある。像の境界に独特の「ハロー」と呼ばれる明るい縁取りができる。 | 図12 位相差観察(ポジティブコントラスト)による 生細胞(カエル血球) |
 図13 ポジティブコントラスト(アスベスト) |  図14 ネガティブコントラスト(アスベスト) |
微分干渉観察法(DIC:Differential Interference Contrast microscopy)
無色透明の標本や生きている細胞などの観察に適した観察方法である。
微分干渉観察では、あたかも物体の斜め上方から光を当てたように物体の輪郭に影が付き、立体的に見える。ただし、物体の勾配の方向によっては見えにくい部分 があることや、実際の標本は観察されているような立体的な形状ではないということ、偏光を利用しているためプラスチックシャーレは使用できないことも覚え ておく必要がある。 |  図15 微分干渉観察による培養細胞 (NG108-15細胞) |
偏光観察法(P、PL:Polarized Light microscopy)
岩石、鉱物の結晶の観察や、物質の複屈折性(入射した光が2つの屈折光に分かれる性質)の検出、測定を行うのに適した観察方法である。
顕微鏡に2枚の偏光板を装着し、偏光の干渉を利用して複屈折性の存在する部分を明暗や色のコントラストに置換えて観察する。
回転ステージを用いて標本を回転させると、複屈折性のある部分が45°ごとに暗く見えたり(消光位)、明るく見えたり(対角位)する。
蛍光観察法(FL:Fluorescence microscopy)
蛍光色素で染色した標本や、標本の蛍光タンパク質から発する蛍光で像を観察する方法である。
一般的に光源には輝度の高い超高圧水銀灯を用い、標本に蛍光を発光させるための光(励起光(れいきこう))を当てる。
蛍光が暗い視野の中で光るので、検出能力が高く、検出したい部位を特異的に識別できる。
標本が自ら光るという点が他の観察方法と大きく異なる。
レリーフコントラスト観察法(RC:Relief Contrast microscopy)
プラスチックシャーレなどの複屈折性のある容器に入れた生細胞の観察に適した観察方法である。
観察には、レリーフコントラスト観察用の対物レンズとコンデンサ(顕微鏡の基礎知識 顕微鏡の構成と仕様 ~照明系~ 5-2.コンデンサ 参照)を装着する。微分干渉観察法のような立体的な像で観察することができる。陰影の向きを統一しているので、対物レンズを換えても見え方は変わらない。 |  図18 レリーフコントラスト観察による人工授精 作例ご協力:東邦大学医学部第一産婦人科安部裕司 先生 |
分散観察法(DS:Dispersion Staining microscopy)
アスベスト(石綿)の計数や定性分析に適した観察方法である。
アスベストを基準波長の屈折率が一致する浸液(インデックスオイル)で封入し、分散対物レンズで観察する。浸液の屈折率によって分散色が異なって見えるという特徴を利用して、アスベストの種類を同定し計数する。ただし、大気中や建材の中には屈折率がアスベストと類似の物質が混在しているため、誤認する可能性が高く、実際の分析には偏光観察法や位相差観察法が併用されている。
観察方法による分類
観察方法名 | 特徴 | 主な利用分野 |
|---|---|---|
明視野観察法 |
・もっとも一般的な観察方法
| ・染色標本の観察 |
暗視野観察法 | ・視野を暗くし、透明な標本を光らせて観察する | ・バクテリアなどの無染色標本の観察 |
位相差観察法 | ・回折光の光路差を明暗のコントラストに置換えて観察する |
・無色透明の標本の観察
|
微分干渉観察法 |
・標本の勾配を利用して色や明暗のコントラストを付けて観察する
|
・無色透明の標本の観察
|
偏光観察法 | ・複屈折性のある部分を明暗や色のコントラストに置換えて観察する |
・岩石や鉱物の結晶の観察
|
蛍光観察法 |
・標本が自ら発する蛍光を利用して観察する
|
・蛍光色素で染色、標識した細胞や組織の観察
|
レリーフコントラスト観察法 |
・標本の凹凸を明暗のコントラストに置換えて観察する
|
・プラスチック容器中の細胞の観察
|
分散観察法 | ・浸液の屈折率の違いによる分散色の変化を利用して観察する | ・アスベストの計数、定性分析 |
その他の顕微鏡
種類 | 概要 | ||
|---|---|---|---|
紫外線顕微鏡 |
・光源に波長の短い紫外線を使うため、分解能が高い
|  | |
赤外線顕微鏡 |
・光源に赤外線を使い、サンプルを破壊することなく内部構造を観察できる
|  | |
測定顕微鏡 | ・長さや高さを高精度測定できる |  | |
ビデオ顕微鏡 |
・標本の拡大像をモニタに表示して観察する
|  | |
超音波顕微鏡 |
・超音波を用い、サンプルを破壊することなく内部構造を観察できる
| ||
共焦点顕微鏡 |
・光源にレーザー光を使う
|  | |
電子
| 透過型電子顕微鏡 |
・標本に電子線をあて、透過した電子を拡大して観察する
| |
走査型電子顕微鏡 |
・標本に電子線をあて、反射した二次電子から得られる像を観察する
| ||
走査型プローブ顕微鏡 |
・先端のとがった探針とサンプルの間に流れる微少な電流(トンネル電流)の変化を利用して結像する。原子間力を利用するものもある
| ||
生物顕微鏡の用途
利用分野 | 用途 |
|---|---|
生物学 | 細胞生物学、分子生物学、生物物理学、発生・遺伝学、細胞生理学、細胞薬理学 |
鉱物学 | 岩石学、無機・有機材料分析 |
教育 | 生物学教育、医学教育、臨床検査学教育 |
検査 | 尿検査、血液検査、喀痰検査、染色体検査、アミロイド検査、組織検査 |
環境・衛生検査 | 上下水道水質検査、微生物検査、粉塵検査、食品分析 |
家畜衛生検査 | 家畜感染症検査、食肉衛生検査 |
金属顕微鏡の用途
利用分野 | 用途 |
|---|---|
材料学 | 金属材料分析、加工物、無機・有機材料分析、結晶分析、粉体検査、金属疲労検査 |
半導体分野 | 基板検査、集積回路検査、チップ検査、異物検査 |
液晶分野 | 液晶材料分析、液晶パネル検査、フィルタ検査、有機ELパネル検査 |
チェックポイント
光を透過する細胞や細菌などの観察には生物顕微鏡、光を透過しない金属表面などの観察には金属顕微鏡を用いる
プレパラート標本での観察には正立型顕微鏡、培養容器での観察には倒立型顕微鏡が適している
一般的な染色標本の観察には明視野観察法が適しているが、無染色標本や生きている標本を観察する場合は、
コントラストを高めるために他のさまざまな観察方法を用いる必要がある
2.プレパラート標本
2-1.プレパラート標本の種類
プレパラート標本とは、観察の対象となるサンプルに処置をして顕微鏡観察に適した形にしたものである。
プレパラート標本は、カバーガラスの有無により「カバーガラス標本」と「ノーカバー標本」に分類できる。
カバーガラス標本
カバーガラス標本は、一定の厚さを持つスライドガラスの上に観察するサンプルを載せ、カバーガラスをかぶせた形の標本である。
スライドガラスの厚さは1~1.2mm、カバーガラスの厚さは0.17mmが標準である。
サンプルの厚さは組織切片で数μm程度である。
永久標本をつくる場合は、封入剤を使用する。
組織切片などの標本は、カバーガラス標本になっている。
カバーガラス標本でサンプルを観察するときは、カバーガラス標本用の対物レンズを用いる必要がある。
|
|
ノーカバー標本
ノーカバー標本は、スライドガラスにサンプルを適当な密度に希釈またはそのまま塗布したものである。
乾燥しても支障のない血液などの塗抹標本はノーカバー標本になっている。
ノーカバー標本でサンプルを観察するときは、ノーカバー標本用対物レンズを用いる必要がある。
|
|
レベルアップ:スライドガラスとカバーガラスの厚さ
スライドガラスとカバーガラスの厚さはJIS規格(スライドガラス:JIS R 3703、カバーガラス:JIS R
3702)で規定されており、生物用の対物レンズはこれらの規格にあわせて設計されている。特にカバーガラスの厚さは0.17mmが標準と定められており、誤差が大きいと観察像は劣化する。対物レンズには、カバーガラスの厚さの誤差を補正できる補正環がついたものも用意されている(顕微鏡の基礎知識 顕微鏡の構成と仕様 ~対物レンズ~ 参照)。
スライドガラスもカバーガラスも、その性能は顕微鏡の観察に大きく影響する。顕微鏡観察を正しく行うには、顕微鏡観察に適した品質のスライドガラス、カバーガラスを使用することが必要である。
チェックポイント
プレパラート標本には、カバーガラス標本とノーカバー標本がある
組織切片などの標本はカバーガラス標本に、血液などの塗抹標本はノーカバー標本になっている
対物レンズには、カバーガラス厚条件(顕微鏡の基礎知識 顕微鏡の構成と仕様 ~対物レンズ~ 2-4.表示 参照)が表示されている
このページはお住まいの地域ではご覧いただくことはできません。









